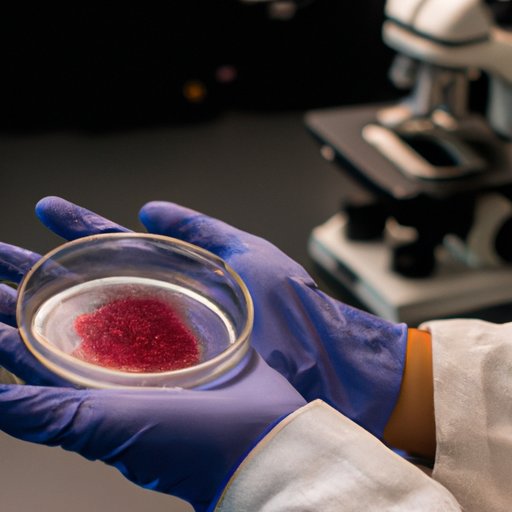

Introduction
Stem cells are a type of undifferentiated cell that have the potential to develop into any cell type in the body. They are incredibly versatile and have the potential to be used for a wide range of medical treatments and therapies. In recent years, there has been an increased focus on understanding and harnessing the power of stem cells for therapeutic purposes. This has resulted in the development of new techniques for culturing stem cells, allowing researchers to better explore their potential uses. In this article, we will explore why the ability to culture stem cells is so important, as well as the potential benefits, challenges and ethical implications of stem cell research.
Exploring the Potential of Stem Cells to Treat Disease
Stem cells are being explored as a potential treatment for a range of diseases. One of the most promising areas of research is their use in treating degenerative diseases, such as Parkinson’s and Alzheimer’s. These diseases are caused by the death of certain types of cells in the brain, and stem cells have the potential to replace these cells and restore lost function. In addition, stem cells can also be used to treat other conditions, such as heart disease, diabetes, and spinal cord injuries.
Researchers are also exploring different types of stem cells and their potential uses. Embryonic stem cells, for example, are derived from embryos and have the potential to become any type of cell in the body. Adult stem cells, on the other hand, are derived from adult tissues and are more limited in their potential applications. Researchers are also looking into induced pluripotent stem cells (iPSCs), which are created by reprogramming adult cells to behave like embryonic stem cells.

The Role of Stem Cells in Regenerative Medicine
Stem cells are also being used in regenerative medicine, which involves repairing or replacing damaged or diseased tissue. This can include restoring lost tissue after injury or illness, or replacing damaged organs with healthy tissue grown from stem cells. Stem cells can be used to regenerate tissue, as they have the ability to differentiate into a variety of cell types. This makes them ideal for tissue engineering and regenerative therapies.
However, there are still many challenges associated with using stem cells for regenerative medicine. For example, it is difficult to control the differentiation of stem cells and ensure that the desired cell type is produced. In addition, stem cells are often sensitive to environmental factors, such as temperature and oxygen levels, which can affect their function and survival. As such, researchers must find ways to optimize the culturing conditions for stem cells to ensure successful outcomes.
How Stem Cells Can Help Us Understand Human Development
Stem cells can also be used to gain a better understanding of human development. Different types of stem cells play different roles during development, and studying them can provide insight into how different tissues and organs form and grow. This information can then be used to identify potential treatments for developmental disorders, such as birth defects and genetic diseases.
In addition, stem cells can also be used to study the impact of environmental factors on development. For example, researchers can use stem cells to study how exposure to toxins or pollutants can alter the development of an embryo or fetus, or how changes in diet or lifestyle can affect gene expression. This information can then be used to develop strategies for preventing developmental disorders.
Advances in Stem Cell Technology and its Impact on Healthcare
Recent advances in stem cell technology have had a major impact on healthcare. For example, scientists have developed new methods for culturing and preserving stem cells, which allows them to be stored for longer periods of time. This has enabled researchers to study stem cells over longer periods of time and better understand their potential uses. In addition, the development of new technologies, such as 3D printing, has made it easier to create custom-made scaffolds for culturing stem cells.
These advances have also had a significant impact on medical practice. For example, stem cell treatments can now be used to treat a wide range of diseases, from cancer to Parkinson’s. In addition, stem cell research and therapy can be used to improve organ transplantation, as well as to develop new treatments for a range of genetic disorders.
The Promise of Stem Cell Therapy for Long-Term Health Outcomes
The potential of stem cell therapy is immense, and it promises to revolutionize healthcare and medicine. Stem cell treatments can provide long-term health benefits, as they can be used to replace or repair damaged tissue. In addition, stem cell therapies may also be able to reverse some of the effects of aging, as they can potentially restore lost function and rejuvenate aging cells.
However, there are still many challenges associated with stem cell therapy, such as cost and safety. As such, further research is needed in order to fully realize the potential of stem cell treatments. Nevertheless, stem cell therapy holds great promise for improving long-term health outcomes and quality of life.

Examining the Ethical Implications of Stem Cell Research
Stem cell research and therapy has raised a number of ethical issues, such as the use of human embryos in research, the potential for “designer babies,” and the exploitation of vulnerable populations. These issues have led to heated debates in the scientific and political communities, as well as among the general public.
It is important to consider these ethical implications when discussing the potential benefits of stem cell research and therapy. It is also important to recognize that not everyone shares the same perspective on these issues, and that different perspectives should be respected. Ultimately, it is up to society to decide what is acceptable when it comes to stem cell research and therapy.
Conclusion
The ability to culture stem cells is an incredibly important part of medical research and therapy. It has enabled researchers to explore the potential of stem cells to treat a wide range of diseases, as well as to investigate the role of stem cells in regenerative medicine and human development. In addition, advances in stem cell technology have had a major impact on healthcare and medicine, and have opened up new opportunities for stem cell treatments. Finally, it is important to consider the ethical implications of stem cell research and therapy when discussing their potential benefits.
(Note: Is this article not meeting your expectations? Do you have knowledge or insights to share? Unlock new opportunities and expand your reach by joining our authors team. Click Registration to join us and share your expertise with our readers.)